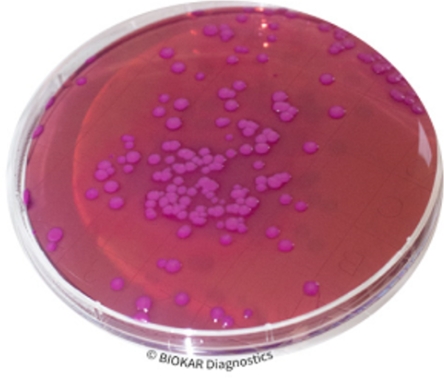
img

CONTACT VRBG + NEUTRALIZERS
CONTACT VRBG + NEUTRALIZERS
Ürün Adı: CONTACT VRBG + NEUTRALIZERS
Ürün Kodu: BM20708
Miktar: 20 Petri plates Ø 65 mm
TECHNICAL DATA SHEET
TDS - Contact VRGB with neutralizers - BM20708_V4
MSDS
Non classification statement_BM207v1
